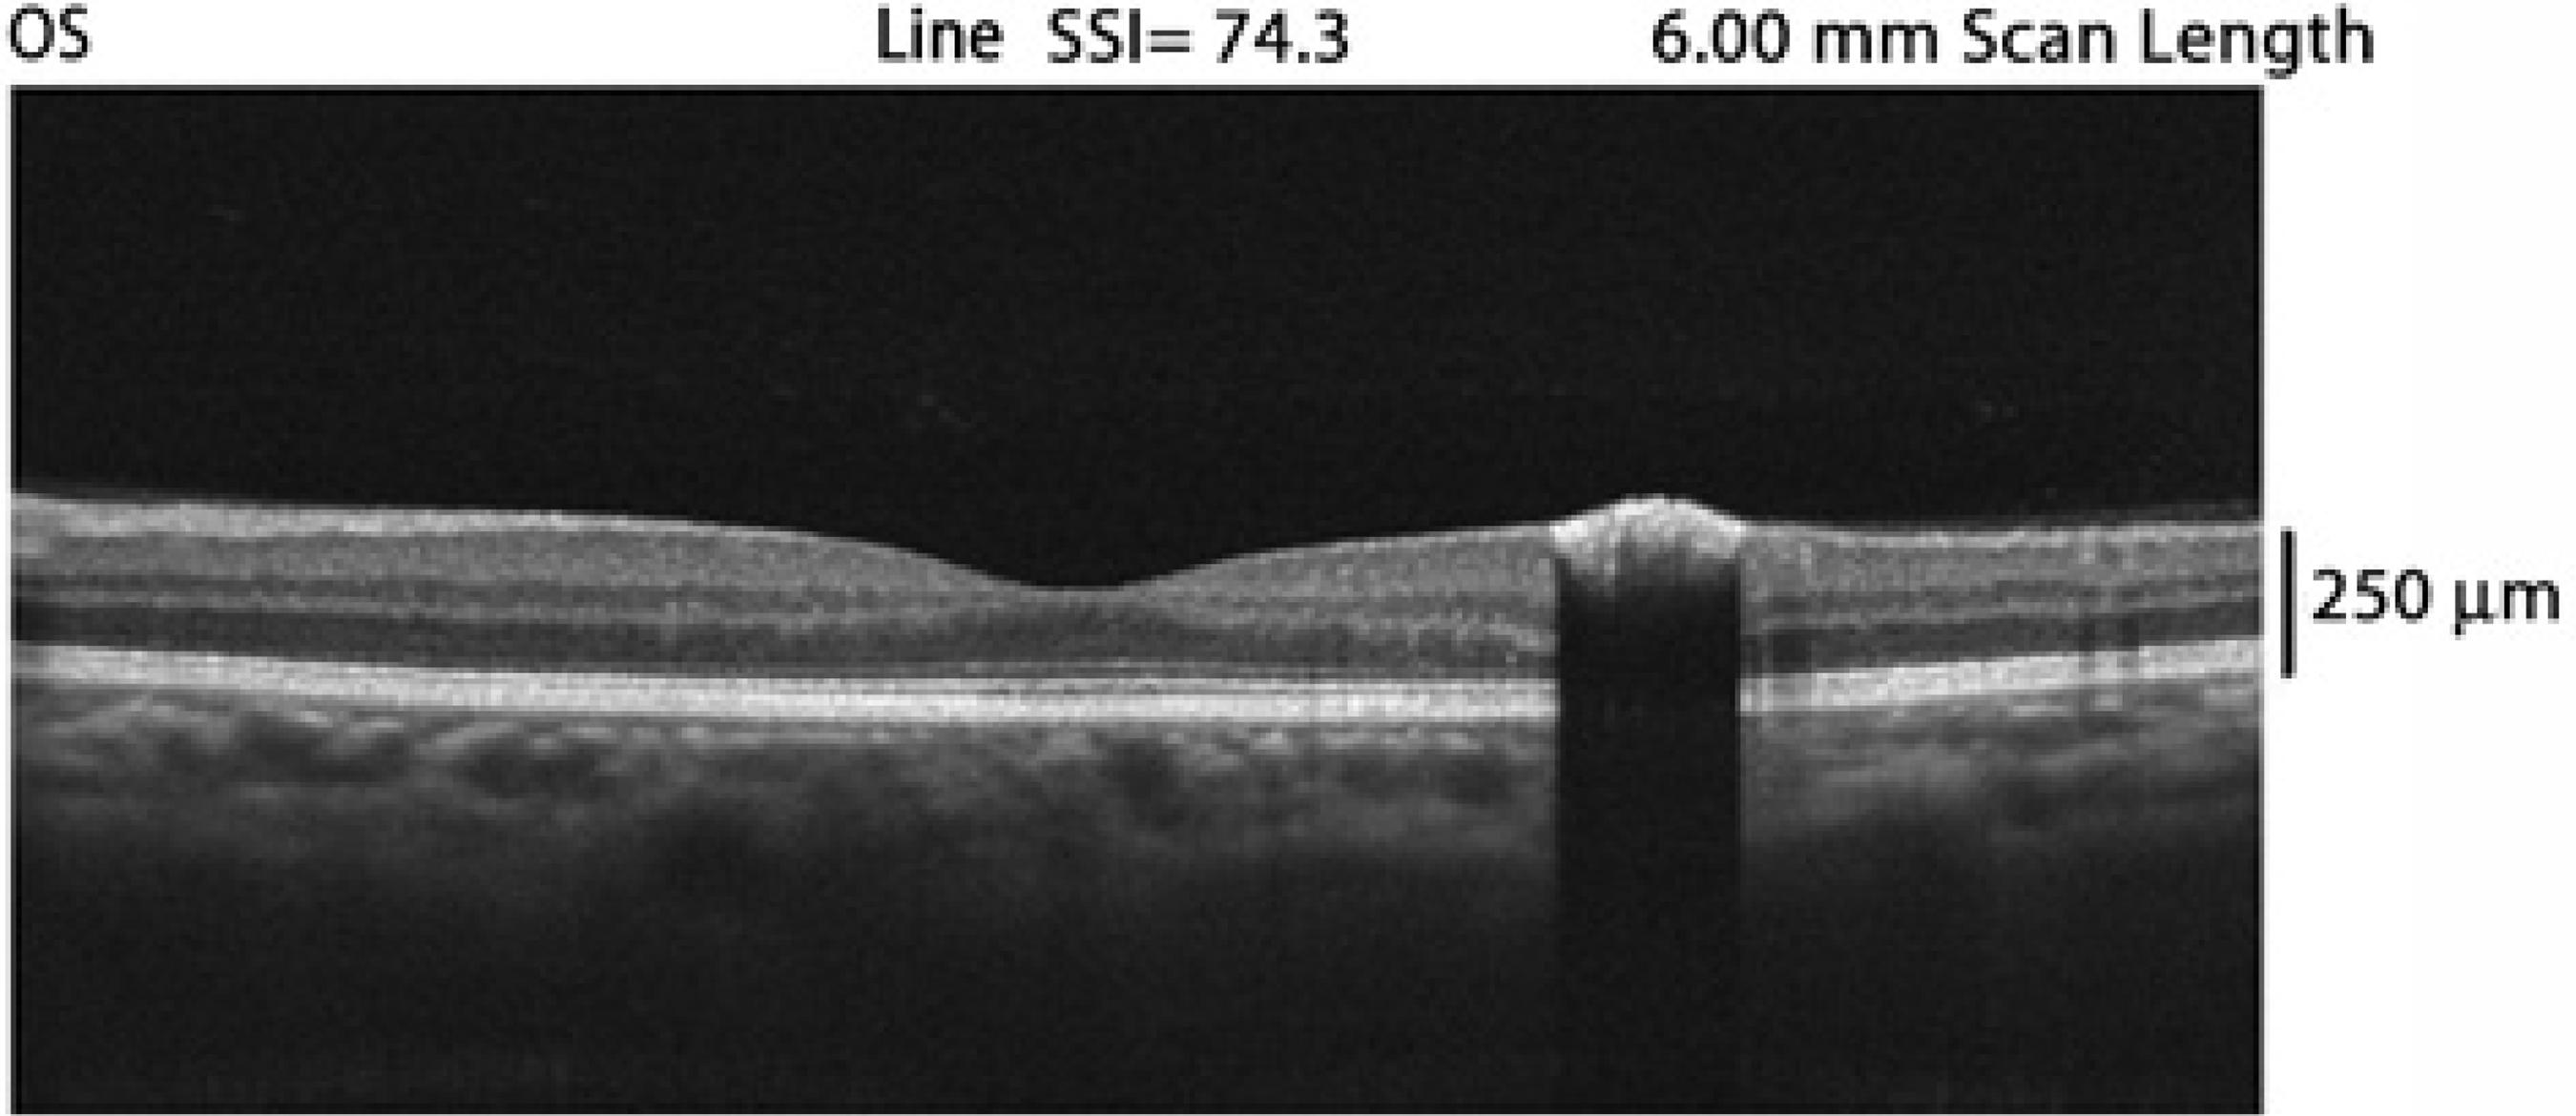

INTRODUCTION
Congenital simple hamartoma of the retinal pigment epithelium (CSHRPE) is an uncommon condition, and few cases have been described in the literature(1,2).It was first discussed by Laqua in 1981(3), and Gass reported three similar cases that he later published in a review of focal congenital anomalies of the retinal pigment epithelium (RPE)(4). This lesion has particular features on fundoscopic examination, fluorescein angiography (FA), and optical coherence tomography (OCT)(5,6).
Tumors of the RPE include congenital hamartoma, congenital hypertrophy, combined hamartoma of the retina and RPE, and adenoma or adenocarcinoma(7,8). In one study, several authors(9) reported on five cases classified as CSHRPE according to their clinical features; all of these lesions maintained a stable pattern during the follow-up period.
Here we describe a case of an asymptomatic 56-year-old woman with a unilateral circumscribed and pigmented fundus lesion suggestive of CSHRPE on clinical examination and confirmed by FA and OCT.
CASE REPORT
A 56-year-old woman was referred for a routine ophthalmic examination to our institution because of a 20-year history of type 2 diabetes treated with insulin. The Snellen best-corrected visual acuity was 20/20 in both eyes, which did not require correction in the right eye and was corrected with a prescription of +0.75 -0.25 X 130° in the left. Biomicroscopy examination was normal, and the intraocular pressure corresponded to 12 mmHg and 10 mmHg in her right and left eyes, respectively. Indirect ophthalmoscopy in the right eye was normal, and in the left eye, there was a circumscribed black posterior pole tumor that was inferotemporal to the fovea. There was no evidence of macular edema, traction, retinal exudation, or subretinal fluid.
Fluorescein angiography and OCT were performed. Angiography revealed a nonfluorescent lesion during all the phases of the examination, including the late phases (Figure 1). OCT revealed an abruptly elevated hyper-reflective mass with deep optical shadowing (Figure 2). The diagnosis was compatible with CSHRPE, and the patient was followed by observation.
DISCUSSION
CSHRPE is a benign tumor that is incidentally diagnosed and involves all layers of the retina. This hamartoma is presumed to be a congenital lesion. It is a rare tumor that can be detected during routine fundus ocular examination. On clinical examination, it appears as a solitary macular lesion that is darkly pigmented, well-defined, and involves the full thickness of the retina. Although FA findings were unremarkable in the present case, hyperfluorescence is occasionally observed in the late phases(1,2). OCT typically shows a complete blockage of optical transmission.
As noted in other reported cases, in this patient, CSHRPE remained stable in size and clinical aspects during the 12 months of follow-up, and the patient remains asymptomatic and without changes in visual acuity. Because of these features, adults are generally diagnosed at an advanced age.
Differential diagnoses include the following: combined hamartoma of the retina and RPE, congenital hypertrophy of the RPE (CHRPE), adenoma or adenocarcinoma of the RPE, hyperplasia of the RPE, intraretinal foreign body, and retinal invasion from an underlying choroidal nevus (melanocytoma) or choroidal melanoma(2). All these can be ruled out by clinical and complementary examinations, as observed in the described patient.
OCT is a useful noninvasive examination that can help in diagnosis and provide information about additional features such as vitreoretinal adhesion(10).
In conclusion, it is very important to identify congenital simple hamartomas of the RPE and follow these patients over the longterm to rule out tumor growth and suspicious malignant features.

English PDF
Print
Send this article by email
How to cite this article
Submit a comment
Mendeley
Scielo
Pocket
Share on Linkedin

